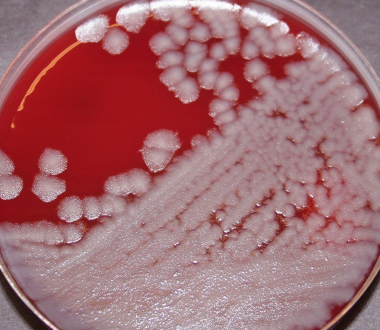

At this year's Laboratory Response Network for Biological Threats Preparedness (LRN-B) Technical Meeting, Biodefense Laboratory Director Michael Perry received the Excellence in Leadership Award for leadership "instrumental to the LRN-B mission" and for "significant contributions" to the field.
The Centers for Disease Control and Prevention (CDC), along with the Association of Public Health Laboratories (APHL), also recognized Wadsworth Center's Biodefense Laboratory with Certificates of Appreciation for the following:
- Participating in the 2023 Resazurin Dye-Based Rapid Antimicrobial Susceptibility Test (RAST) Study
- Through their contributions to this multicenter study, the Biodefense Laboratory helped reduce the time to susceptibility results on isolated B. anthracis from up to 20 hours to approximately four hours.
- Contributing to mpox extraction platform validation
- The Biodefense Laboratory validated an automated extraction platform during the 2022 mpox response. This method, which was faster than the manual method, was released to the other labs in the network, increasing the capability and capacity of mpox testing.
- Quality control testing of challenge panels
- The Biodefense Laboratory was acknowledged for their work in validating each round's samples. All laboratories participating in the Laboratory Response Network routinely take CDC-prepared proficiency tests.
More about Wadsworth Center's Biodefense Laboratory
Analysis of clinical and environmental samples for the presence of highly pathogenic organisms is the primary focus of the lab. The lab develops, validates, and implements new technology in the field of applied diagnostics and is actively involved in training first responders and clinical laboratorians.
Working with federal agencies such as the CDC, as well as innovative technology-based companies and manufacturers, the lab develops, tests, and validates cutting edge devices for the detection of biothreat agents.
The NYS DOH Wadsworth Center Biodefense Laboratory is:
- One of 14 Advanced Laboratory Response Network labs in the US capable of providing capacity for rapid response to biothreat events
- One of 12 labs in the US receiving FDA funding as a Food Defense Microbiology Laboratory
- USDA funded Food Emergency Response Network (FERN) laboratory
- The Biodefense Laboratory:
- Has BSL2 and BSL3 high containment laboratory space
- Utilizes an All-Hazard Receipt Facility (one of two commissioned by US DHS) for screening of environmental threat samples